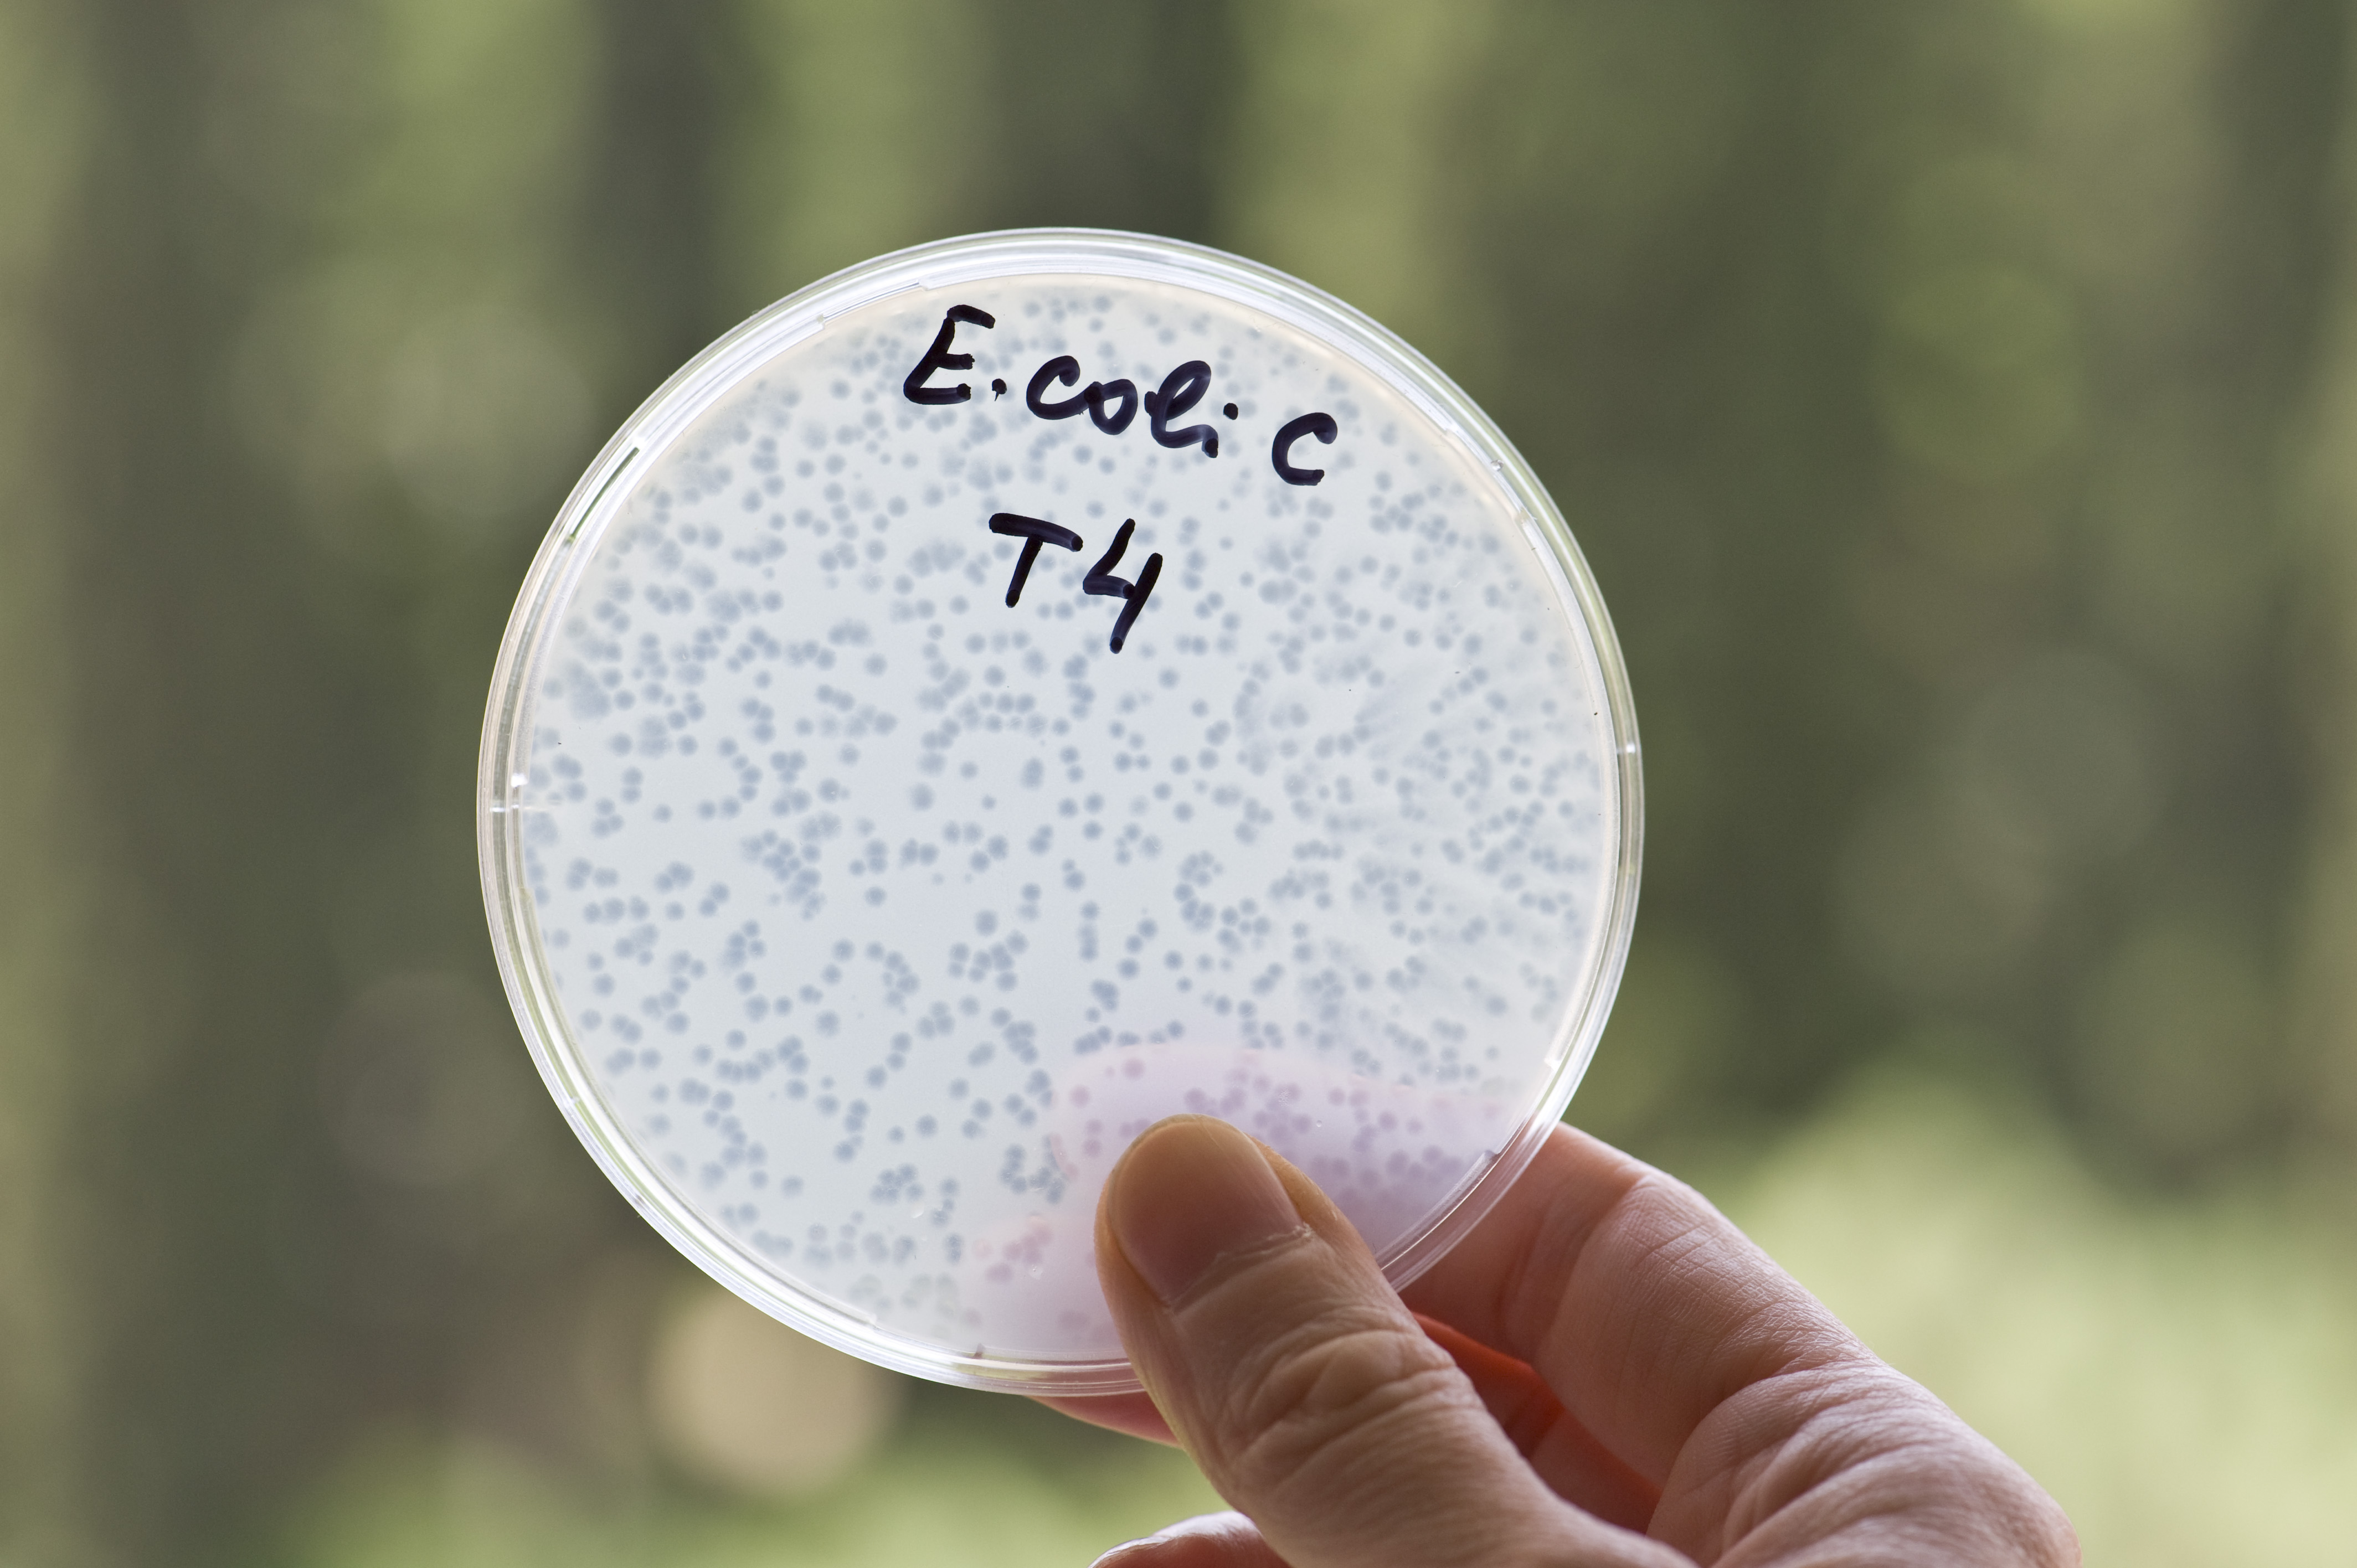
4th International Eliava Summer School on Bacteriophage Research: Hands-On Phage Preparation for Therapeutic Use

About Eliava Institute
George Eliava Institute of Bacteriophages, Microbiology and Virology, based on its rich traditions, continues its research in applied microbiology and on bacteriophage studies.
Our mission:
Transfer of our unique knowledge about bacteriophages from generation to generation and the further development of the field; Creation of new phage preparations and evaluation of their application potential in various fields.

Museum and Library
The Library is one of the most significant and complete collections of scientific books, journals and periodicals in microbiology and bacteriology. Many unique issues and original publications are preserved in the library.
The Museum is located in the main building of the Eliava Institute. Archival photo-materials of the history and activities of the Institute are preserved in the museum.